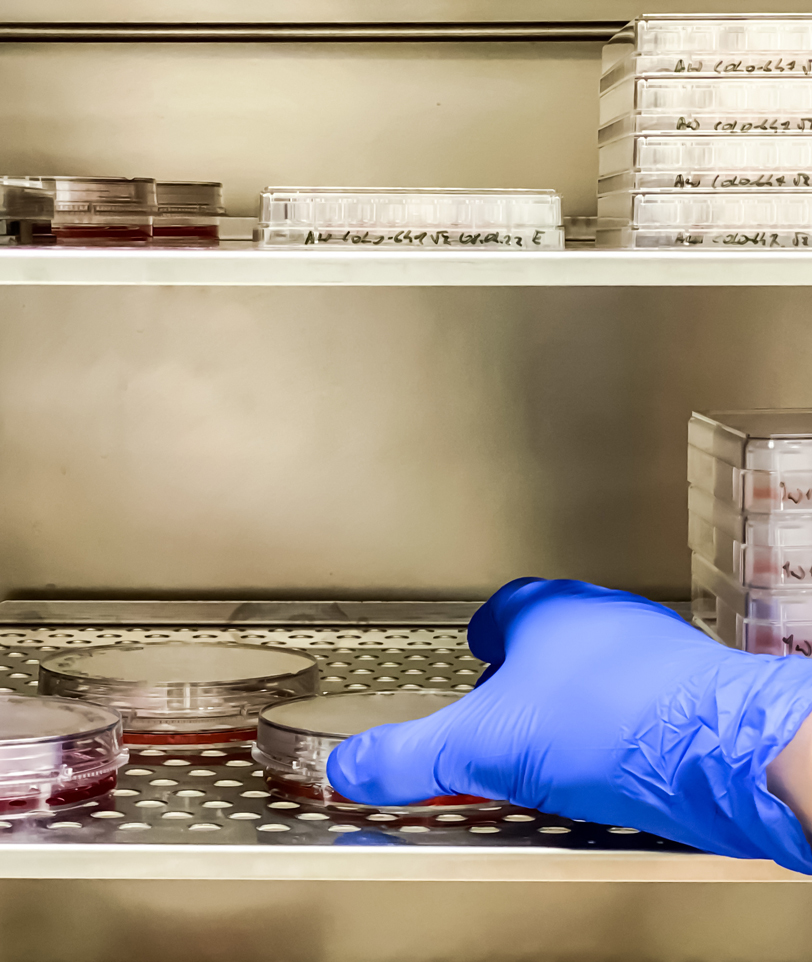

The KPMG SAP Journey Makers program brings together leaders in utilities—spanning finance, IT, and program management—to collaborate, learn, and share practical insights on SAP transformation journeys. Our program includes in-person and virtual sessions where peers can collaborate on various aspects of their transformation journey, while also obtaining guidance from SAP leaders and subject matter experts in their field of interest. The program provides deep education in support of the SAP journey, including:
A Documentary
As patients advocate for themselves and professionals innovate in both treatments and healthcare systems, a collective effort can be made to usher in a new era of healthcare.
Click to watch video

Key themes on the SAP journey
Program branding and value definition are key to aligning team structure and enhancing engagement.��
Project security perceptions and transparent communication counteract rumors and build trust.��
Talent management, supported by executive alignment, drives team efficiency and morale.
�
Learn more about the

Contact us

View website
Leverage KPMG’s deep SAP skills and experience, methodologies, and industry-specific frameworks to structure your own SAP journey effectively.��
Participate in interactive discussions on change management, leadership alignment, and resource planning, drawing upon KPMG’s established tools and techniques.
Leading guidance and proven framework

View website
Build a compelling, business-led case for transformation, centered around ROI, operational efficiency, and regulatory considerations.��
Learn how to define, track, and realize value early and often—through Phase 0 planning, execution, and hypercare enhancement.
Focus on measurable business value
What does the KPMG Journey Maker program provide?
KPMG leaders speak to the SAP journey in energy
Zoe Thompson
Principal, Energy and Chemicals SAP Leader�KPMG US
Watch my video
Richard Gray
Lung cancer patient
Director, Dolomite
Unchained Labs
Todd Durocher
Principal, Power and Utilities Transformation Leader�KPMG US
People


View article
KPMG Executive Insights: How Utilities can Navigate Complex Business Transformation
KPMG perspectives for utilities when considering SAP
How do I get involved?
KPMG SAP Journey Makers
Revolutionizing and modernizing the Utility industry
Unleashing the power of SAP S/4HANA

View insights
KPMG supports an energy supplier with their transformation
SAP S/4HANA implementation at EnBW

View article
How S/4HANA Enables Utility Transformation
Powering the Energy Orchestrator
Reimagining the Utility Role
The Energy Orchestrator operating model

View article
Navigating Utility Transformation in an Era of Tech Disruption, Climate Uncertainty and AI Innovation
The Energy Orchestrator



View article

View article




Precision medicine has the power to revolutionize healthcare and transform clinical outcomes for patients. But how do we fully tap into its potential?
Click to watch documentary trailer

View website
Shared problem-solving: Get advice from experienced utilities to overcome challenges. � �
Structured roadmap: Leverage KPMG’s frameworks for phased, iterative transformation.��
Reduced risk: Identify pitfalls early, enhance change management, and ensure aligned governance.��
Talent and culture development: Develop strategies to retain and upskill talent throughout long transformations.��
Ongoing networking: Join future events to refine approaches, receive feedback, and stay updated on emerging SAP best practices.
Benefits of joining:

View website
Gain firsthand knowledge from utilities at various stages of their SAP S/4 transformation—what works, what doesn’t, and how to avoid pitfalls. �t�
Hear success stories, lessons learned, and leading practices from peers who have recently navigated similar challenges.
Access to peer insights and practical experiences

View website
Join a dedicated network of utilities, SAP and industry specialists exchanging ideas on governance, technology decisions, and program culture.��
Continue the conversation beyond one-off meetings by attending roundtables, sharing updates, and receiving ongoing support as your transformation matures.
Collaborative community and continual support




View agenda
KPMG Lakehouse May 3–5, 2025�SAP Journey Makers session agenda
SAP Power and Utilities Journey Makers session

Join us
Kristin Ciriello Pothier
US Life Sciences Industry Leader and US and Global Deal Advisory and Strategy Leader, Healthcare and Life Sciences, KPMG LLP
Guiding energy utilities on the SAP transformation journey
Alasdair Milton
Principal, Healthcare and Life Sciences Strategy, KPMG LLP
Dr. Varun Renjen
Managing Director, Life Sciences Deal Advisory and Strategy, KPMG LLP
Jessica Lin
Principal, Healthcare and Life Sciences Strategy, KPMG LLP
Jeff Stoll
Principal, National Strategy Lead, Life Sciences, KPMG LLP


Read bio

Read bio


Read bio


Read bio


Read bio
















Fostering a business-led focus: Building a compelling business case that centers on tangible business value and ROI rather than technology obsolescence��
Proactive change management: Integrating change management early in the process, engaging end-users, and ensuring organizational readiness to boost trust and buy-in��
Leadership alignment: Involving decision-makers at the right time and providing clear communication of goals, scope, and expectations across teams��
Keeping scope lean: Limiting complexity where possible and involving business users early to de-risk transformation and drive immediate adoption��
Embracing continuous improvement: Using feedback loops, lessons learned, and success stories from peers to iterate and enhance processes as the transformation matures
"I think one of the most exciting things that's going on in the market in general with technology is around AI. When it comes to SAP, it is at the forefront, and it's changing the fundamental way that we will interact with solutions going forward." ��– Todd Durocher
"We're gathering S/4 leaders together to share
insights, challenges and perspectives on their roadmaps.
They run very similar programs and business operations
depending on what geography they're in. The collaboration
around how they are moving forward on some of their
biggest challenges drives a lot of value for each participant." ��– Brad Stansberry
On every S/4HANA transformation, there are a set of key roles that must be filled within the program ecosystem. These roles can be filled by one or multiple providers. Our view on each role is described below:
Key business transformation program roles

As patients advocate for themselves and professionals innovate in both treatments and healthcare systems, a collective effort can be made to usher in a new era of healthcare.
Click to watch video
The vendors or partners providing the technology (SAP) and platform solutions (hyper-scalers) offer support, insights, and experience on the technology being implemented and the platform that will run it.
Transformation strategy



As patients advocate for themselves and professionals innovate in both treatments and healthcare systems, a collective effort can be made to usher in a new era of healthcare.
Click to watch video
Integrating key business areas into the project scope ensures comprehensive value realization.��
MVP definition and roadmap clarity are essential for actionable and achievable goals.��
Data and regulatory considerations are foundational to defining project success and limits.�
Scope and business case

As patients advocate for themselves and professionals innovate in both treatments and healthcare systems, a collective effort can be made to usher in a new era of healthcare.
Click to watch video
Selecting the right technological tools and establishing clear governance structures that support business objectives improves chances for success.��
End-to-end process definition and data governance lay the groundwork for success.��
Continuous communication and defined design principles are crucial for organizational alignment and readiness.
�
Business preparedness

Platform
Aligning transformation efforts directly with business needs enhances focus and outcome.��
Clear role definitions and communication are vital for stakeholder engagement.��
A strategic deployment approach, considering future challenges, streamlines integration and value delivery.
Want to be apart of the Journey Makers group?



Quality supports the transformation's success by rigorously upholding standards, validating system functionality, and maintaining alignment with project requirements and objectives.
Quality

Orchestration aligns the transformation's strategic direction and execution, ensuring that program goals are met and value is realized through effective program and benefits management.
Orchestration

Manage the quality, integrity, and availability of data throughout the S/4 transformation. This includes data migration, data governance, data cleansing, and data integration to support the successful implementation and utilization of the S/4 system.
Data

Technology ensures the transformation's success by architecting a secure, integrated, and scalable IT environment that supports current operations and paves the way for future innovation and growth.
Technology

Foster engagement and readiness by developing and implementing strategies for training, communication, and organizational design that center on enhancing employee experiences throughout the transformation.
People

Business helps shape and realize the transformation vision, crafting a strategic path that aligns with industry standards and operational goals, emphasizing robust governance and data-driven decision-making.
Business

View insights
Upgrading Sarbanes-Oxley (SOX) controls as part of an SAP-based customer service management implementation
Making compliance a key element in a major utility's transformation
Ready to accelerate your SAP transformation journey? Join our exclusive peer group of utility executives in the KPMG Journey Makers program. Together, we’ll share leading practices, and exchange real-world lessons to drive meaningful, measurable value. Contact us today to reserve your spot at our next event—and start transforming your organization with the support of a powerful network of industry leaders.

Join here
Join us

View insights
Essential strategies for success
Unlocking SAP value after selecting your System Integrator
Want to be apart of the Journey Makers group?

Join here
Brad Stansberry
Energy and Chemicals Advisory Leader
KPMG US
Watch my video
Watch my video






View insights
KPMG speaks SAP
KPMG and SAP�Business and technology transformation


View website
Gain firsthand knowledge from utilities at various stages of their SAP S/4 transformation—what works, what doesn’t, and how to avoid pitfalls. �t�
Hear success stories, lessons learned, and leading practices from peers who have recently navigated similar challenges.
Access to peer insights and practical experiences


Healthcare systems were not designed to deliver precision medicine, meaning that we must work together to address the challenges that prevent us from ensuring equitable access to this revolutionary care.
Join us on this journey as we launch KPMG Connections in Precision Medicine, a documentary featuring key stakeholders in the healthcare ecosystem, including patients, pathologists, physicians, researchers, payers, and industry representatives, sharing their unique perspectives. Filled with compelling stories, we cover a wide range of topics, from the potential of cutting-edge technologies such as liquid biopsy and next-generation sequencing, to the development of new business and operating models for the healthcare sector. As we eagerly anticipate the release of our full documentary in February 2024, we invite you to join us in exploring this critical and transformative field.
A Documentary
As patients advocate for themselves and professionals innovate in both treatments and healthcare systems, a collective effort can be made to usher in a new era of healthcare.
Click to watch video

© 2024 KPMG LLP, a Delaware limited liability partnership and a member firm of the KPMG global organization of independent member firms affiliated with KPMG International Limited, a private English company limited by guarantee. All rights reserved.
For more detail about the structure of the KPMG global organization, please visit https://home.kpmg/governance.





Featured stories and insights
Richard Gray
Chureen Carter
Kelli J. Brooks
Terri Conneran



Irene M. Kang,
MD
Edward S. Kim, MD, MBA, FACP, FASCO
Melissa B. Davis, PhD
Gabriel A. Bien-Willner, MD, PhD, FCAP

KPMG Connections in Precision Medicine

Listen to powerful stories from patients, industry experts, and healthcare providers about how precision medicine has empowered their healthcare decisions, providing renewed hope to them, their families, and future generations.
Learn more about the

KPMG Precision Medicine practice

View website
The Janssen Pharmaceutical Companies of Johnson & Johnson is now Johnson & Johnson Innovative Medicine. Learn who we are and what our purpose is—leading where medicine is going.
Introducing Johnson & Johnson Innovative Medicine | Home (janssen.com)

View website
KRAS Knowledge + Research + Advocacy = Survivorship
Founded by patients for patients as a nonprofit for any KRAS oncogene or cancer type.
KRAS Cancer (KRAS Kickers) Research
Resources
Patient perspectives
Speakers
Terri Conneran
KRAS lung cancer patient
Founder KRAS Kickers
Kelli J. Brooks
Office Managing Partner – Principal
Advisory Forensic
KPMG LLP
Richard Gray
Lung cancer patient
Director, Dolomite
Unchained Labs
Chureen Carter
Breast cancer patient
Data Scientist
Irene M. Kang, MD
Medical Director, Women’s Health Medical Oncology,
City of Hope Orange County
Assistant Professor, Department of Medical Oncology & Therapeutics Research, City of Hope
Edward S. Kim,
MD, MBA, FACP, FASCO
Senior Vice President & Physician-in-Chief, City of Hope Orange County & Vice Physician-in-Chief & Professor, City of Hope National Medical Center
Melissa B. Davis, PhD
Director, Institute of Translational Genomic Medicine, Georgia Research Alliance Distinguished Investigator, Professor of Microbiology Biochemistry and Immunology, Morehouse School of Medicine Atlanta, GA
Gabriel A. Bien-Willner,
MD, PhD, FCAP
Chief Medical Officer, Palmetto GBA
Program Medical Director, MolDX
Healthcare provider
Andrew McKenzie, PhD
Vice President, Personalized Medicine
Sarah Cannon &
Scientific Director
Genospace
Dawn Cardeiro, MS
Director of Precision Medicine
Clinician Innovation
Point32Health
Ralph Riley
Johnson & Johnson Innovative Medicine
Precision Medicine Access Strategy
Bonnie H. Anderson
Founder, CEO and Chair
PinkDx, Inc.
Industry
Patient
Medical professionals must unite in pursuit of advancing precision medicine and improving patient outcomes.
Video – Coming soon
Healthcare provider
Andrew McKenzie, PhD
Dawn Cardeiro, MS
Ralph Riley
Bonnie H. Anderson
Leaders across the life sciences industry are working together to build an ecosystem that can fully enable precision medicine.
Click to watch video
Industry



View insights
We are on the precipice of precision medicine in neurodegenerative diseases (NDDs)
The Dawn of Precision Medicine in Neurodegenerative Diseases
Explore related content
KPMG Connections in
Precision Medicine
Ep 1: Precision medicine’s role in neurodegenerative disease
KPMG Connections in Precision Medicine Podcast Series
Duration: 9:48

View insights
The future of life sciences will likely be shaped by tech-enabled connectivity, strategic uses of AI, and patient-centric supply chains.
The future of life sciences is connected, AI-driven, and patient-centric

View article
KPMG perspective on this innovative technology
Liquid Biopsy – What’s real and what’s hype?
A near-term niche?
“One-and-done” gene therapies

View article
KPMG perspective on this innovative technology
Spatial omics – microenvironments in full resolution



Podcast

View article






















Precision medicine has the power to revolutionize healthcare and transform clinical outcomes for patients. But how do we fully tap into its potential?
Click to watch documentary trailer

View website
Program (FT3) is a nonprofit multistakeholder collaborative program that aims to unify, accelerate, and build on existing efforts to make precision medicine a reality for all patients who could benefit from it.
From Testing to Targeted Treatments Program

View website
Sarah Cannon, the Cancer Institute of HCA Healthcare, offers integrated cancer treatments with access to cutting-edge therapies for those facing cancer in communities across the United States and United Kingdom.
Expert Cancer Care Navigated Close to Home – Sarah Cannon

View website
City of Hope is a100-plus-year-old, National Cancer Institute (NCI)-designated comprehensive cancer center. As pioneers in cancer research, treatment, and prevention, they bring breakthroughs from the laboratory to patients at speed.
Top Cancer Treatment and Research Center – City of Hope

View website
Point32Health is a leading nonprofit health and well-being organization, delivering a better healthcare experience to the communities they serve.
This way to better health – Point32Health

View insights
The unprecedented impact of generative AI across the precision medicine landscape
A new era of precision medicine


© 2024 KPMG LLP, a Delaware limited liability partnership and a member firm of the KPMG global organization of independent member firms affiliated with KPMG International Limited, a private English company limited by guarantee. All rights reserved.
For more detail about the structure of the KPMG global organization, please visit https://home.kpmg/governance.
















Video – Coming soon

Contact us
Kristin Ciriello Pothier
US Life Sciences Industry Leader and US and Global Deal Advisory and Strategy Leader, Healthcare and Life Sciences, KPMG LLP




Driven by the evolution in our understanding of the genetic and molecular drivers of disease, precision medicine has the power to change how we treat diseases like cancer.
Healthcare provider
Industry
Patient perspectives
Healthcare provider
Industry
Patient perspectives
Alasdair Milton
Principal, Healthcare and Life Sciences Strategy, KPMG LLP
Dr. Varun Renjen
Managing Director, Life Sciences Deal Advisory and Strategy, KPMG LLP
Jessica Lin
Principal, Healthcare and Life Sciences Strategy, KPMG LLP
Jeff Stoll
Principal, National Strategy Lead, Life Sciences, KPMG LLP


Read bio

Read bio


Read bio


Read bio


Read bio








View website
Our vision is to lead the creation and advancement of health equity.
Morehouse School of Medicine
















Data
Risk and Regulatory
ESG
Digital Transformation and
Platform Tech Modernization
CM&AM
Insurance
Banking
Cross FS

Lorem ipsum dolor sit amet, consectetur adipiscing elit, sed do eiusmod tempor incididunt ut labore et dolore magna aliqua. Ut enim ad minim veniam, quis nostrud exercitation ullamco.
Click to hear from [placeholder]
Lorem ipsum dolor sit amet, consectetur adipiscing elit, sed do eiusmod tempor incididunt ut labore et dolore magna aliqua. Ut enim ad minim veniam, quis nostrud exercitation ullamco laboris nisi ut aliquip ex ea commodo consequat. Duis aute irure dolor in reprehenderit in voluptate velit esse cillum dolore eu fugiat nulla pariatur. Excepteur sint occaecat cupidatat non proident, sunt in culpa qui officia deserunt mollit anim id est laborum. Sapien faucibus et molestie ac feugiat sed.
Click to hear [placeholder]
video series
Connections in
Precision Medicine

© 2023 KPMG LLP, a Delaware limited liability partnership and a member firm of the KPMG global organization of independent member firms affiliated with KPMG International Limited, a private English company limited by guarantee. All rights reserved.
For more detail about the structure of the KPMG global organization, please visit https://home.kpmg/governance.





Patient


Image
Lorem ipsum dolor sit amet, consectetur adipiscing elit, sed do eiusmod tempor incididunt ut labore et dolore magna aliqua. Ut enim ad minim veniam, quis nostrud exercitation ullamco laboris nisi ut aliquip ex ea commodo consequat. Duis aute irure dolor in reprehenderit in voluptate velit esse cillum dolore eu fugiat nulla pariatur. Excepteur sint occaecat cupidatat non proident, sunt in culpa qui officia deserunt mollit anim id est laborum. Sapien faucibus et molestie ac feugiat sed lectus.
Richard Gray
Chureen Carter
Kelli J. Brooks
Terri Conneran

Irene M. Kang,
M.D.
Edward S. Kim, M.D., M.B.A., FACP, FASCO
Melissa B. Davis,
PhD
Gabriel A. Bien-Willner, MD, PhD, FCAP

Lorem ipsum dolor sit amet, consectetur adipiscing elit, sed do eiusmod tempor incididunt ut labore et dolore magna aliqua. Ut enim ad minim veniam, quis nostrud exercitation ullamco laboris nisi ut aliquip ex ea commodo consequat. Duis aute irure dolor in reprehenderit in voluptate velit esse cillum dolore eu fugiat nulla pariatur. Excepteur sint occaecat cupidatat non proident, sunt in culpa qui officia deserunt mollit anim id est laborum. Sapien faucibus et molestie ac feugiat sed.
Click to hear [placehoider]
Healthcare Provider
Andrew McKenzie, PhD
Dawn Cardeiro, MS
Ralph Riley
Bonnie H. Anderson

Lorem ipsum dolor sit amet, consectetur adipiscing elit, sed do eiusmod tempor incididunt ut labore et dolore magna aliqua. Ut enim ad minim veniam, quis nostrud exercitation ullamco laboris nisi ut aliquip ex ea commodo consequat. Duis aute irure dolor in reprehenderit in voluptate velit esse cillum dolore eu fugiat nulla pariatur. Excepteur sint occaecat cupidatat non proident, sunt in culpa qui officia deserunt mollit anim id est laborum. Sapien faucibus et molestie ac feugiat sed.
Click to hear [placeholder]
Industry
Documentary
heading placeholder
Promo heading placeholder
Lorem ipsum dolor sit amet, consectetur adipiscing elit, sed do eiusmod tempor incididunt ut labore et dolore magna aliqua. Ut enim ad minim veniam, quis nostrud exercitation ullamco.
Explore related content




Lorem ipsum dolor sit amet, consectetur adipiscing elit, sed do eiusmod tempor incididunt ut labore et dolore magna aliqua. Ut enim ad minim veniam, quis nostrud exercitation ullamco.


Image
KRAS Cancer (KRAS Kickers) Research

View website

KPMG PM webpage

View insights
We are on the precipice of Precision Medicine in neurodegenerative diseases (NDDs)
The Dawn of Precision Medicine in Neurodegenerative Diseases
The Janssen Pharmaceutical Companies of Johnson & Johnson is now Johnson & Johnson Innovative Medicine. Learn who we are and what our purpose is—leading where medicine is going.
Introducing Johnson & Johnson Innovative Medicine | Home (janssen.com)
Image

View website